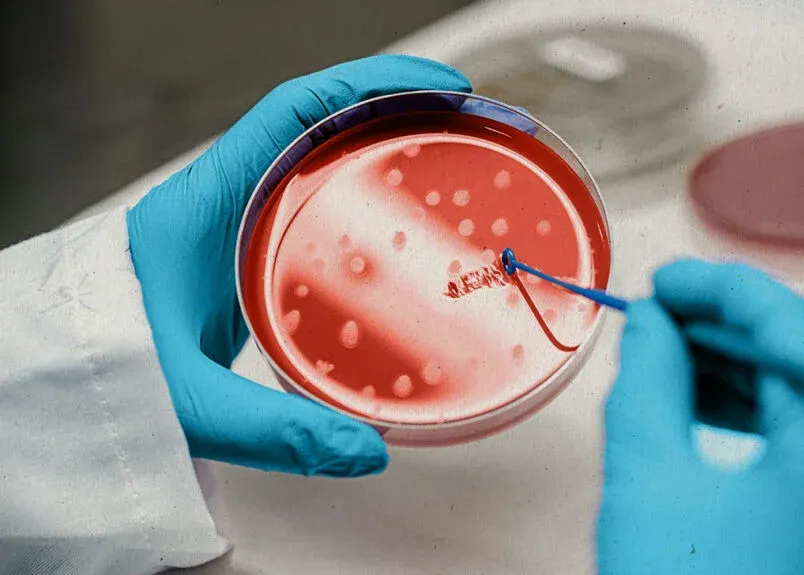
سلول بنیادی

فیستول مقعد یکی از مشکلات شایع نشیمنگاهی است که به صورت یک ارتباط غیر طبیعی بین کانال مقعد و سطح پوست اطراف آن مشخص می شود. فیستول ناشی از عفونت مزمن غدد مقعدی است و با درد زیادی همراه است. درمان های رایج فیستول مقعد شامل جراحی هایی نظیر فیستولوتومی است ولی به دلیل مشکلات و عوارض پس از جراحی از جمله عدم بهبود کامل یا آسیب به اسفنکتر مقعد روش های غیر جراحی ترجیح داده می شوند.
یکی از روش های نوین درمان فیستول مقعدی استفاده از سلول های بنیادی است. ویژگی های ترمیمی و توانایی در بازسازی بافت های آسیب دیده این سلول ها به درمان فیستول با کمترین عوارض کمک می کند. این روش کم تهاجمی یک گزینه درمانی موثر برای بیمارانی است که از فیستول مقعد رنج می برند. توجه داشته باشید که استفاده از سلول های بنیادی در درمان فیستول مقعد هنوز در مراحل تحقیقاتی و آزمایشی است و بطور گسترده مورد استفاده قرار نمی گیرد. با اینحال نتایج اولیه نشان می دهد که این روش می تواند به عنوان یک رویکرد کارآمد برای درمان فیستول مورد استفاده قرار بگیرد.

فیستول مقعدی چیست و چه علائمی دارد؟
فیستول مقعدی یک مجرای غیر طبیعی بین کانال مقعد و سطح پوست اطراف آن است که به دلیل عفونت غدد مقعدی رخ می دهد. فیستول ها از نظر پیچیدگی و محل متفاوت هستند و به دو دسته ساده و پیچیده تقسیم بندی می شوند. فیستول های ساده تنها یک مجرا دارند اما فیستول ها پیچیده مجاری متعددی دارند. فیستول ها جهت درمان به مداخلات پزشکی نیاز دارند و خود به خود درمان نخواهد شد. مهمترین علامت فیستول مقعدی درد و ناراحتی در ناحیه مقعد است که هنگام نشستن، حرکت یا اجابت مزاج افراد مبتلا را آزار می دهد.
خروج چرک از مجرا یکی دیگر از علائم شایع فیستول مقعد است که با بوی بد همراه است. در برخی موارد، فیستول باعث خونریزی شده و با تورم و التهاب در نزدیکی مقعد یا پوست اطراف آن مشخص می شود. علاوه بر این در موارد شدیدتر فیستول مقعدی منجر به تب و عفونت های مکرر خواهد شد.
برای درمان فیستول مقعد با بهترین روش های موجود می توانید به کلینیک التیام نشیمنگاه مراجعه نمایید. متخصصان با تجربه این مرکز در کوتاه ترین زمان ممکن انواع فیستول مقعدی را درمان می کنند.
سلول بنیادی چیست و چه کاربردی دارد؟
سلول بنیادی (Stem Cell) سلول هایی هستند که توانایی تمایز به انواع مختلف سلول های تخصصی بدن را دارند. آنها به صورت نامحدود تقسیم می شوند و نقش اساسی در ترمیم و بازسازی بافت های بدن دارند. سلول های بنیادی انواع مختلفی دارند و در پزشکی برای درمان بیماری ها و آسیب ها، درمان زخم ها و سوختگی ها و همچنین در تحقیقات دارویی مورد استفاده قرار می گیرند. این سلول ها در بازسازی بافت های آسیب دیده از جمله فیستول نیز نرخ موفقیت بالایی دارند.

عملکرد سلولهای بنیادی در درمان فیستول مقعد چگونه است؟
تزریق سلول های بنیادی برای درمان فیستول در سال های اخیر بسیار مورد توجه قرار گرفته است. همانطور که گفته شد سلول های بنیادی توانایی بازسازی بافتی و ترمیم آسیب ها را دارند. این سلول ها با تحریک فرآیندهای ترمیم طبیعی کمک می کنند تا مسیر فیستول بطور طبیعی بسته شود و بافت های اطراف آن بهبود یابند.
سلول های بنیادی پس از تزریق با ترشح فاکتورهای رشد و تکثیر سلول های سالم منجر به بهبود سریع تر و بازسازی بافت های آسیب دیده شده و به بستن مجرای فیستول کمک می کنند. همچنین با خواص ضد التهابی می توانند التهابات ناشی از عفونت های مزمن فیستول را کاهش دهند بنابراین به کاهش احتمال عود دوباره فیستول کمک می کنند.
بخوانید: جراحی فیستول با پلاگین بیوپروتز + درصد موفقیت و هزینه + فیلم جراحی
درمان فیستول مقعد با سلولهای بنیادی چه مزایایی دارد؟
تزریق سلولهای بنیادی یک روش کم تهاجمی است که نیازی به برش های بزرگ یا بخیه ندارد. این روش در مقایسه با روش های جراحی عوارض کمتری دارد. علاوه بر این به دلیل طبیعی بودن فرایند ترمیم که با تکثیر سلول های بنیادی اتفاق می افتد دوره نقاهت خاصی در این روش وجود ندارد.
خصوصا این روش برای فیستول های مقاوم به درمان و عود کننده بسیار مفید است. علاوه بر این بیمارانی که از فیستول های مقعدی پیچیده و چندگانه رنج می برند، می توانند از سلول های بنیادی به عنوان جایگزین جراحی های پیچیده و پرخطر استفاده کنند. نرخ موفقیت بالا در درمان فیستول های مقاوم به درمان یکی دیگر از مزایای کاربرد سلول های بنیادی در درمان فیستول مقعد است.

محدودیت های درمان فیستول مقعد با سلولهای بنیادی
با وجود مزایای بالقوه ذکر شده در رابطه با استفاده از سلول های بنیادی در درمان فیستول مقعدی هنوز چالش ها و محدودیت های متعددی در این روش وجود دارد. یکی از این موارد اثربخشی متغیر سلول های بنیادی است بنابراین گاهی اوقات در درمان فیستول کاملا موفق عمل نمی کند.
این روش هزینه بالایی دارد و دسترس پذیری آن در مراکز درمانی فعلا محدود است. از آنجاییکه این روش هنوز در مرحله تحقیق است تاثیرات بلند مدت تزریق سلولهای بنیادی هنوز به طور کامل مشخص نشده است و نیازمند تحقیقات بیشتر است.
برای درمان چه نوع فیستولی می توان از سلول های بنیادی استفاده کرد؟
سلول های بنیادی بیشتر برای درمان فیستول مقعدی مزمن و مقاوم به درمان کاربرد دارند. خصوصا فیستول های مقعدی که با جراحی معمول مانند فیستولوتومی درمان نشده و بطور مکرر عود می کنند با تزریق سلول های بنیادی درمان خواهند شد. زیرا سلولهای بنیادی می توانند به بازسازی بافت و ترمیم مسیر فیستول کمک کرده و از عود دوباره آن جلوگیری می کنند.
درمان جراحی فیستول های مقعدی پیچیده به دلیل ساختار و موقعیت بسیار دشوار است. سلول های بنیادی به دلیل قابلیت ترمیم بافت های آسیب دیده، می توانند بطور موثرتری این نوع از فیستول ها را درمان کنند.
همچنین در مواردی که فیستول مقعدی به داروهای ضد التهابی، آنتی بیوتیک ها یا جراحی های سنتی پاسخ نمی دهد سلولهای بنیادی یک گزینه بسیار موثر هستند که به بهبود فیستول و کاهش التهاب کمک می کنند. استفاده از این روش یکی از بهترین گزینه های درمان فیستول مقعد است زیرا هیچ آسیبی به بافت های مقعدی وارد نمی کند.

درمان فیستول با سلول بنیادی در ایران ممکن است؟
این روش نوین درمانی محدود به مراکز تحقیقاتی است و در برخی کشور های نوین و مراکز خاص مورد انجام قرار می گیرد. در ایران متاسفانه هیچ مرکزی چنین شیوه نوین درمانی برای درمان فیستول انجام نمی دهد. و در بیمارستان ها بیشتر جراحی سنتی و در کلینیک ها همچون کلینیک التیام نشیمنگاه روش های جدیدتر ماند درمان با لیزر co2 انجام می شود.




